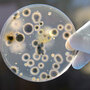

Luke Skywalker
Super Moderator
{vb:raw ozzmodz_postquote}:
![]()
hide captionThat stethoscope may have more germs than you'd expect. A simple wipe with alcohol can solve the problem, but when's the last time you saw that?
iStockphoto
A trip to the doctor's office may help you feel better, but it can also send you right back to bed if you're unlucky enough to pick up someone else's germs during your visit.
And researchers say you might be getting those germs from the doctor's stethoscope.
[h=3]Health Care[/h] [h=3]Catching Hospital Workers Dirty-Handed[/h]
Think of stethoscopes as an extension of the doctor's hands, which are the main source of patient-to-patient bacterial transmission, says Didier Pittet, the director of infection control at University of Geneva Hospital in Switzerland and the study's lead author.
The Center for Disease Control estimates that on any given day, one in every 20 patients has an infection after receiving medical care. Between 30 to 40 percent of those infections happen through the spread of pathogens from one patient to another or from hospital equipment to a patient, often via the hands of healthcare workers, according to Gonzalo Bearman, an epidemiologist at Virginia Commonwealth University, who wasn't involved in the study.
But while there are guidelines that recommend that all doctors wash their hands before and after visiting each patient, there are none mandating that small medical equipment like stethoscopes should also be disinfected after every single use.
"We have no guidelines to clean our stethoscopes, which has as many bacteria on the diaphragm of the stethoscope as we have on our fingertips," Pittet tells Shots.
To study this, researchers had three physicians examine a total of 83 patients at the hospital. After each examination, they looked at the amount of bacteria collected on different regions of physician's dominant hand and on the diaphragm – the part that comes in direct contact with the patient – and tube of their stethoscopes.
[h=3]Author Interviews[/h] [h=3]MRSA: The Drug-Resistant 'Superbug' That Won't Die[/h]
In one phase, researchers examined total bacteria collected; in another, they focused just on one particularly bad bug, methicillin-resistant Staphylococcus aureus or MRSA, to see if the contamination includes disease-causing bacteria.
Although results from 12 patient examinations showed no presence of bacteria, the remaining 71 revealed that the density of bacteria was much higher on the stethoscope than on the back and palm of the hand. The most heavily contaminated parts were the fingertips, and the more contaminated they were, the more bacteria was found on the stethoscope.
The results were published Thursday in Mayo Clinic Proceedings.
Pittet considers the study one of the first to provide evidence that health care providers should clean their stethoscopes. But he says it may be years before any guidelines actually come out. That's because research has yet to show just how many patient-to-patient infections are associated with the spread of bacteria through medical equipment.
Science Diction: The Origin Of 'Stethoscope' Nov. 25, 2011
"One of the major knowledge gap of infection control is the degree to which the inanimate environment ... actually drives the hospital infection process," Bearman says. "We haven't been able to come up with great studies that say, 'Well if you do a certain degree of decolonization, you're going to get an absolute reduction in infections' ."
But, he adds, "Common sense should dictate that reusable equipment should be wiped down after each use."
The solution sounds simple enough: doctors can use an alcohol-based rub to clean their equipment or use disposable covers. Though Bearman notes that many people still don't do either.
And that's true for hand washing, too, which both Bearman and Pittet stress is the most important practice. In the 1990s, just 50 percent of doctors washed their hands between patients. Since the initial hand hygiene campaign by the World Health Organization, Pittet says the number has improved to nearly 70 percent worldwide.
"However, it is not at that very high, high rate of sustainability that we would like to see," Bearman tells Shots.
That's why both scientists say that patients shouldn't be afraid to ask their doctors to not only to clean the equipment, but also their hands before the examination. (Tip: If you find the situation uncomfortable, you can talk to your nurse.)
"Those hands are coming into contact with multiple potential sources of pathogens, whether it's touching the telephone, touching the bed rails, touching the patients, touching the IV line, touching the stethoscope," Bearman says. "So the final common link is going to be the hands of the healthcare workers."
![]()